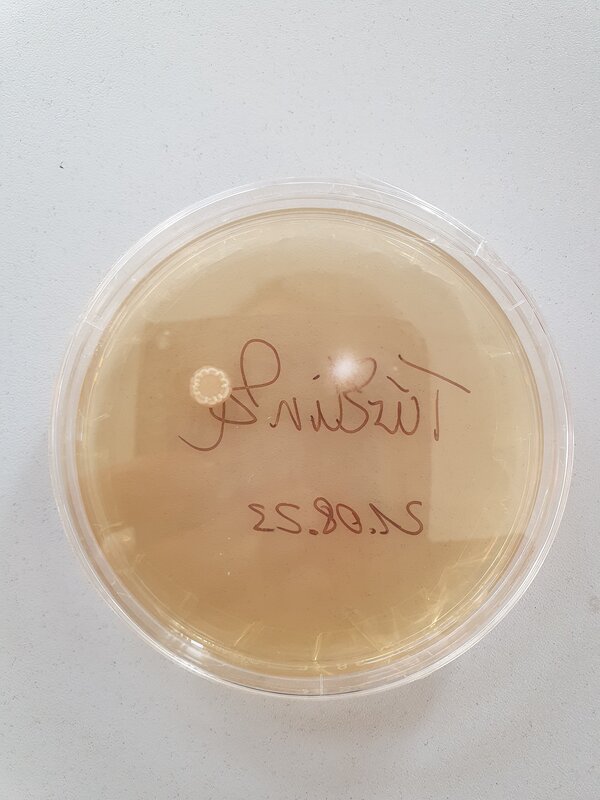
Reha-Ausbildung integrativ: Hurra, unsere neuen Azubis sind da!

NULL


Reha-Ausbildung integrativ: Hurra, unsere neuen Azubis sind da!
Die Reha-Ausbildung integrativ startete am 15.08.2023 mit 4 Auszubildenden für Fachpraktiker Hauswirtschaft und 1 Auszubildenden für Fachpraktiker Küche.
Die ersten Tage dienten dem Kennenlernen ihres Ausbildungsbetriebes, der Ausbilder und der Berufsschule. Die nächsten Wochen stehen im Fokus der Kompetenzfeststellung. Unser Schwerpunkt hier liegt in der ressourcenorientierten Arbeit. Durch verschiedene Tests in den schulischen Kernfächern sowie den praktischen und sozialen Kompetenzen ermitteln wir den möglichen Förderbedarf, um unsere Azubis bestmöglich während ihrer Ausbildung unterstützen zu können. Neben Konzentrationstraining, Teamfindungsangeboten und der Heranführung an die praktischen Arbeiten, führen wir kleine Projektwochen zu verschiedenen Themen durch. Während der Projektwochen zur Hygiene, standen kleine Experimente zu Bakterien, Viren und & Co. im Mittelpunkt. So haben wir Proben von Gegenständen und unseren Händen genommen und Kulturen angelegt. Die Ergebnisse haben uns sehr erstaunt.
Quelle Bilder: Euro-Schulen Bitterfeld-Wolfen